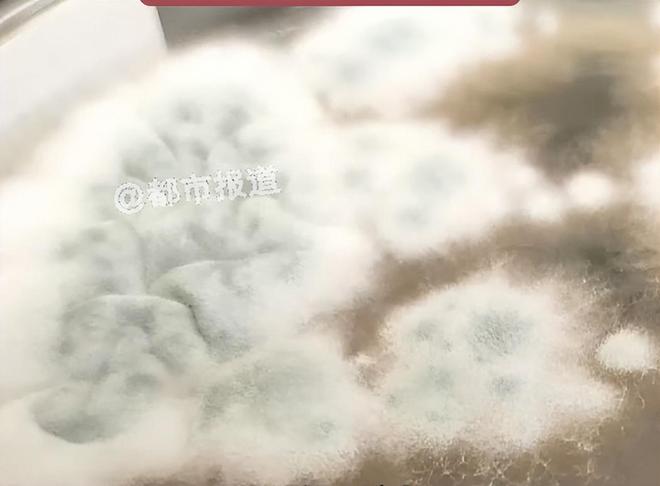
手术中面罩意外砸眼 患者复查发现右眼眼球有线头残留

手术中面罩意外砸眼 患者复查发现右眼眼球有线头残留
手术中面罩掉落砸眼致视力严重下降

手术中面罩意外砸眼 患者复查发现右眼眼球有线头残留示意图
眼部手术过程中,硅胶面罩意外砸到患者眼部。术后数月,马先生一直觉得眼睛存在异物感、眼干、分泌物多、视力严重下降等多种问题。对此,院方的说法为,马先生眼部问题与面罩意外砸中无太大关系。双方就责任划分及赔偿问题未达成一致。
孩子在潮湿环境中玩耍后

医生介绍
上海一男子关节疼痛、头晕恶心,得了怪病?医生:家里有问题;挪开衣橱大吃一惊......
该工作人员表示,至于眼部残留线头的情况,因她不是参与调解此事的负责人,不太了解情况,无法给出明确答复,“但我们很明确,患者的眼部问题我们一定会继续尽心治疗,也会针对我们存在的问题给予合理的补偿,但患者提出的补偿金额太高,暂时未能达成一致。”
新民晚报(xmwb1929)综合都市报道、大象新闻、新闻坊
2月6日,记者从马先生提供的门诊病历及住院病历上看到,2025年5月30日24小时内入出院记录显示,“患者17月前无明显诱因出现右眼视力下降,就诊于我院,诊断为‘右眼孔源性视网膜脱离’,并于2023年11月3日行右眼玻璃体切除剥膜激光注硅油术,手术顺利,术后定期门诊复查,现为取出眼内硅油遂收住我科,拟行进一步手术治疗。”
本想着手术后右眼视力能有所恢复,然而右眼硅油取出手术却成为他新一轮困境的开始。他回忆道:“手术结束,我从麻药中刚刚苏醒过来时,清楚地感觉到有东西砸到了我的右眼。”
孩子脑子被“啃”出大大小小十几个洞 诊疗影像截图
马先生称,从2025年12月初至今,他多次与院方沟通协商,院方未对其责任和赔偿等问题给予明确答复。这让他非常着急,“我现在因为眼睛问题没法干活,家里没有收入来源,眼睛要是治不好,以后生活可咋办?”
医生让他查下自己家里面的情况
霉菌通过呼吸道进入血液系统
记者联系到西安一家三甲医院医患关系办公室负责人,他告诉记者,每家医院都会设置医患科、医调办等机构,遇到医患纠纷,患者应第一时间向这些科室反映,此类科室会向当事部门、科室及相关人员了解、核实情况,并采取院内医疗质量安全评估等方式,在查清事实、分清责任的基础上提出处理意见,并按约定的时限及时反馈给投诉人。对于情况较复杂、需调查、核实的投诉事项,于5个工作日内向投诉人反馈相关处理情况或处理意见;涉及多个科室,需组织、协调相关部门共同研究的投诉事项,一般会在10个工作日内向投诉人反馈处理情况或处理意见。
医生找到了“真凶”——烟曲霉菌
他在移开一个衣橱后
手术过程中面罩意外砸眼,患者术后多种不适 资料图
随即,院方帮马先生将残留的线头取出。这次的检查结果令马先生坚信,该院在2025年5月为其进行的右眼硅油取出术和术后几次复查均存在问题。
该负责人还提醒,患者最重要的是及时固定证据,尤其是病历资料、检查报告、缴费凭证、沟通录音等是维权的核心依据。发生纠纷后,应立即要求医疗机构封存和复制病历,防止证据灭失。“建议优先通过协商或调解方式解决,以降低时间和经济成本,如果涉及严重损害或责任争议较大,应及时咨询专业律师,通过法律途径维护权益。”
否则会影响健康
堆满了建筑垃圾、生活垃圾
右眼被砸中感觉有痛感,医护人员说多观察
孩子脑子竟被“啃”出大大小小十几个洞
被确诊有类风湿,还有偏头痛!
新民晚报此前就曾报道过
时常感觉四肢疼痛
延伸阅读
马先生告诉记者,他当时感觉右眼有种伤口被撕裂开的痛感,从手术室被推到病房后,他明确告知医生及护士,术中面罩砸到了刚完成硅油取出术的右眼,但当时医护人员均未多说什么,只说多观察。
院方承认存在面罩砸眼情况,称患者提出补偿金额过高
近日
马先生是咸阳旬邑县人,父亲去世后,母亲和哥哥靠低保维持生计。马先生离异,抚养四岁儿子,创业失败留下债务,银行账户被冻结,他的基本生活难以为继。
工作人员最后说,将继续积极与患者协商沟通,力争解决问题。
去医院检查
多次与院方沟通协商,院方没有给出明确答复
据媒体消息
家中日常要注意勤开窗通风
孩子被烟曲霉菌感染 资料图
6岁女孩发烧17天意识不清,医生检查后大吃一惊:脑子被“啃”出十几个洞,差点被“啃空”!
术后眼部百般不适,患者疑与术中意外有关
医生检查后大吃一惊
进而“爬”进脑子
2023年,马先生的右眼被诊断为视网膜脱落。2023年11月,马先生在西安市人民医院航天城院区接受了硅油填充术。因经济比较拮据,本应术后半年进行的右眼硅油取出术,一直拖到2025年5月30日才在该院进行。
发现衣橱后的窗外
华商报大风新闻记者 马群 编辑 赵瑞利
因霉菌而感染生病
编辑:施雨
需及时处理
意识不清转至郑州治疗
河南一6岁女童发烧17天
头部有发昏情况
术后眼部一直存在异物感、眼干、视力下降等问题,并未好转,马先生称,术后几次复查,他均向医生告知了自己眼部的种种不适,“医生一直跟我说,这些症状是视网膜脱落后不可逆的现象,仅仅给开了眼药水,但滴了眼药水也一直没啥用。”从2025年5月30日进行了右眼硅油取出手术后,他一直遵医嘱复查,但眼部的不适并未减轻,这不仅让他怀疑医生的医术,更担心这些症状与术中面罩砸眼的意外有关。
出院情况为:患者生命体征平稳,无特殊不适,敷料包扎完好无渗液。术后日间病区观察2小时,患者无术眼不适。
烟曲霉菌常隐藏在潮湿的环境中
记者联系到西安市人民医院航天城院区医调办。工作人员称,马先生在右眼硅油取出术中,确实存在面罩意外掉落在其眼部的情况,这一点院方并未回避,“我们也觉得非常抱歉,但马先生眼部的问题本身就比较严重,他目前的情况,跟这次意外并没有太大的关系。”
如发现有发霉地方
2025年12月9日,复诊门诊初诊病例则显示,初步诊断结果为双眼人工晶体植入状态;左眼中心性浆液性脉络膜视网膜病变;干眼症。
抽取洞内积液检测后
房间角落墙面、衣柜里都有霉斑!
术后4个月、半年复查时,门诊病历显示,双眼人工晶体植入状态;右眼高眼压症;右眼视网膜动脉供血不足;干眼症。
实在疼得吃不消
医生提醒
“涉及医疗损害责任争议的,我们会告知投诉人可通过医疗纠纷人民调解委员会调解或诉讼等途径解决,并做好解释疏导工作。”该负责人称,医患协商是最直接的方式,但当双方分歧较大时,往往难以达成一致。行政调解是向卫生行政部门申请处理,而司法诉讼则是最后的解决途径。

专业人士:建议优先通过协商或调解方式解决,降低维权成本
再晚来几天可能会被“啃空”
在马先生的强烈要求下,2025年12月初,该院为马先生换了一名医生检查,而此次的检查结果令马先生十分意外,“不仅查出我右眼眼球有线头残留,还查出我左眼中心性浆液性脉络膜视网膜病变。之前复查那么多次,怎么就没查出来呢?”
上海的周先生
编审:陈莉